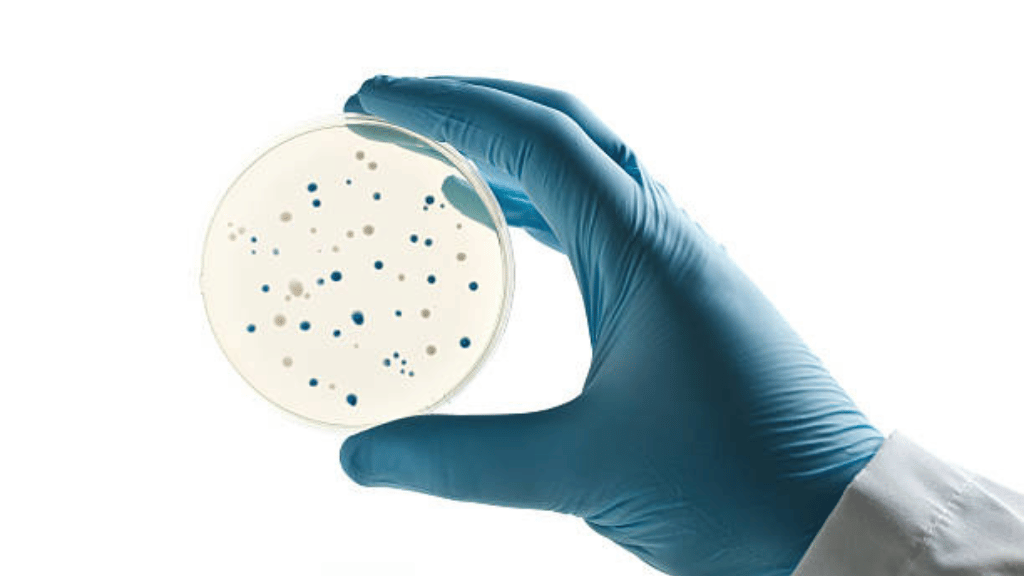

WATER & WASTEWATER TREATMENT

We provide sustainable and efficient solutions for industrial water and wastewater management. Using advanced technologies, we reduce organic load, control odor, improve biodegradability, and ensure compliance with discharge norms. Our products enhance plant performance, lower operational costs, and promote water recycling and reuse with environmental responsibility.
ENZYMES FOR INDUSTRIAL PROCESSES

Our specialized enzymes deliver higher efficiency, improved yields, and reduced energy use across multiple industries. From distilleries and food to textiles and biofuels, our solutions enable faster, cleaner, and more sustainable production. We help businesses achieve excellence, optimize operations, and reduce their environmental footprint.
Sugar and Distillery Process Chemical

We offer advanced biochemical solutions that enhance sugar and distillery operations. By ensuring higher sugar recovery, faster fermentation, and superior alcohol yields, our products minimize by-products while maximizing reliability. This results in sustainable growth, improved cost efficiency, and consistent peak performance for the industry.
ANTIMICROBIALS AND BIOCIDES
Our high-performance disinfectants and biocides provide effective microbial control and longer system life. Developed for industrial applications, they deliver hygiene, safety, and reliability while ensuring compliance with regulations. These solutions support sustainable, cost-effective operations and protect processes with advanced microbial defense.
Agricultural Industry

Advanced nutrient formulations and next-generation bio-solutions crafted to strengthen soil vitality, accelerate plant growth, and unlock higher crop yields. Designed to empower modern agriculture, our innovations drive consistent productivity and measurable results for progressive farming.
Innovative Solutions
We leverage cutting-edge biotechnology and sustainable science to create solutions that optimize performance. Our innovations are designed to deliver efficiency and lasting impact for our partners.
Proven Excellence
We combine deep expertise with a commitment to quality. Our solutions drive efficiency and performance across diverse industries, setting new standards for what's possible.
Sustainable Partnerships
We partner with industry leaders to build a greener future. Our collaborations balance productivity with sustainability, creating a positive impact for everyone.
CERTIFICATIONS




TRUSTED BY LEADERS











